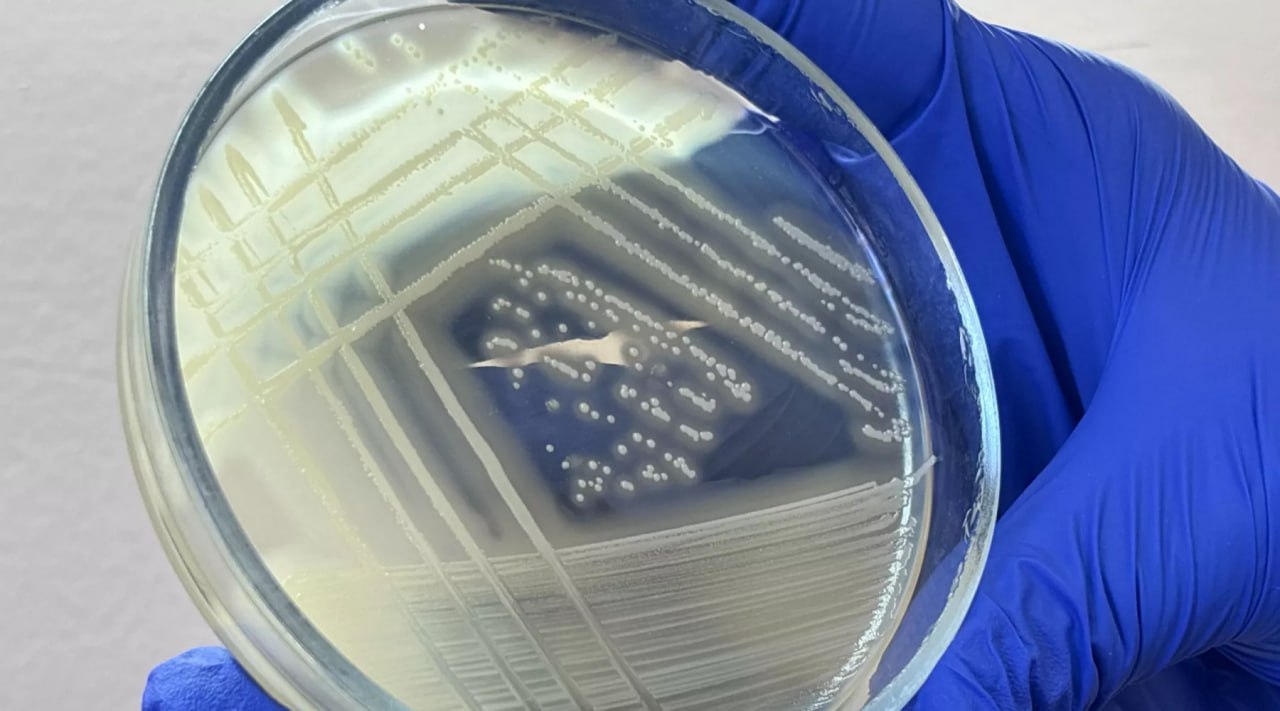

Роскачество выявило золотистый стафилококк в готовом холодце бренда "Ремит", а также бактерии кишечной палочки в продукции торговых марок "Диво", "Ашан" и "Раменский деликатес"
Всего микробиологические нарушения обнаружены в продукции 9 торговых марок. Это свидетельствует о серьёзных сбоях в санитарно-гигиеническом контроле на производстве или в логистике. Превышение общего количества микроорганизмов (КМАФАнМ) выявлено у брендов "Окраина", "Ремит", Super, "Вкусвилл", "Диво", "Ашан", "Раменский деликатес", "Торговая площадь", "Холодушка". Кроме того, в холодце "Ашан" обнаружены сульфитредуцирующие клостридии.
Эксперты также проверили образцы под микроскопом и выявили, что холодец торговой марки "М" содержал субпродукты, не заявленные в составе. В брендах "Super" и "Диво" выявлены не указанные в составе консерванты (бензойная кислота), в продукции бренда "Холодушка" заявлено неверное содержание белка, а бренда "Мясной выбор" - неверное содержание углеводов.
Фото Евгения Плахотина